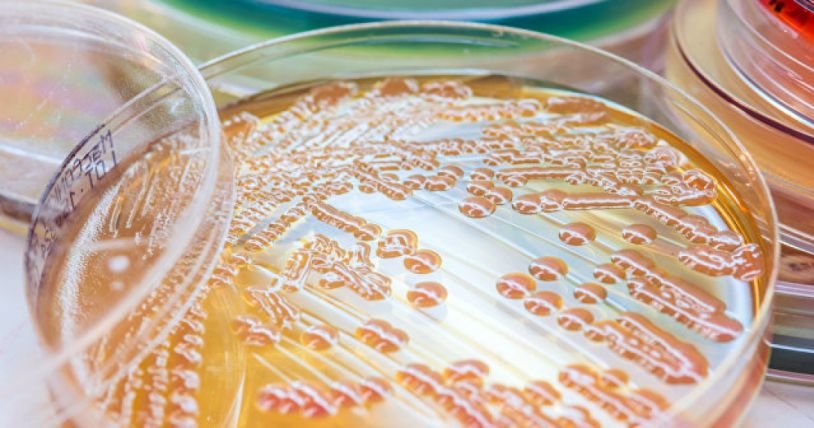
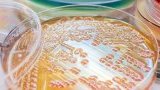

Малко е известно за това как някои патогенни бактерии като Pseudomonas aeruginosa взаимодействат в група в присъствието на антибиотици. Изследователи от САЩ са установили, че причинителите на пневмония, сепсис и други инфекции общуват помежду си, за да избягват антибактериалните агенти, съобщи "Сайънс дейли, цитиран от БТА.
В първото по рода си изследване на подобен тип поведение, специалисти от университетите на Нотр Дам, Индиана, и на Илинойс са установили, че комуникирайки помежду си, бактериите подават сигнали за стрес, когато са застрашени от антибиотици.
Отделяният в подобна ситуация химикал, наречен алкил хидроквинолон, вероятно активира защитни механизми, допринасящи за антибиотичната резистентност на бактериите, която се превръща в нарастваща заплаха за общественото здраве.

Добави коментар